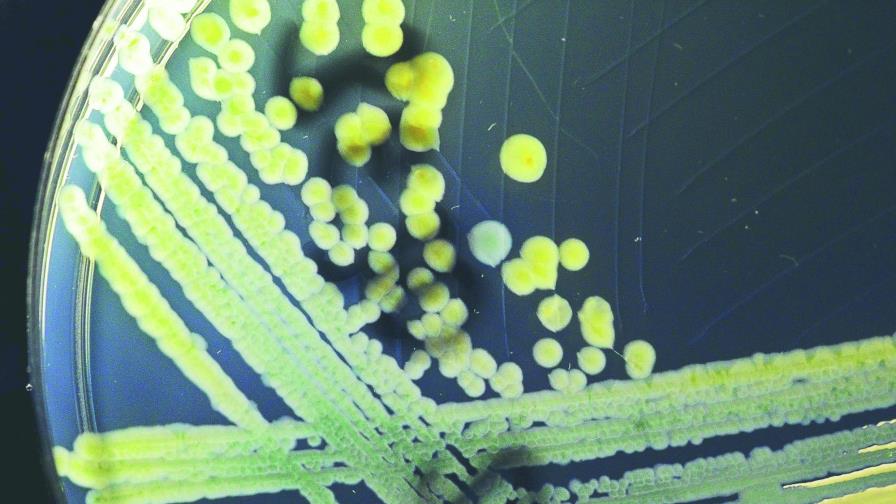
Cuatro superbacterias  afectan a latinoamericanos

Cuatro superbacterias afectan a latinoamericanos
Bogotá. Investigadores de la Universidad del Bosque de Colombia lograron identificar, tras más de quince años de trabajo, las cuatro bacterias “súper resistentes” a los antibióticos que más afectan a los latinoamericanos, en especial en hospitales.
Según el trabajo de los expertos, gérmenes como la “Escherichia coli”, la “Klebsiella pneumoniae”, la “Pseudomonas aeruginosa” y el “Staphylococcus aureus” han adquirido capacidades para vencer a los antibióticos y su número aumenta en Latinoamérica. “Estas son las cuatro ‘superbacterias’ con una gran capacidad de volverse resistentes y además causar múltiples infecciones en los pacientes hospitalizados”, explicó a la investigadora sénior Virginia Villegas.
En el caso de la peligrosa “Escherichia coli”, la experta señalóque es una bacteria causante de infecciones urinarias e intraabdominales, mientras que la “Klebsiella pneumoniae”, que se ha vuelto “superresistente”, produce neumonías y bacteriemias.
En tanto, el “Staphylococcus aureus” produce cierres en piel, además de colonizar y generar daños en catéteres y prótesis, y la “Pseudomonas aeruginosa” causa neumonías violentas e infecciones severas que los pacientes contraen en el área de cuidados incentivos.
Villegas añadió que los primeros tres microorganismos pueden vivir en el tracto gastrointestinal de los pacientes y desde allí infectarlos cuando estén hospitalizados, gracias a la baja de defensas o a la “situación de estrés que enfrentan”, pasando a la sangre o al pulmón o a la orina. En tanto, la “Pseudomonas aeruginosa” está en la piel de las personas y de allí ingresa al cuerpo a través catéteres.
“Toda esta resistencia se ha diseminado en el mundo. Hay una tendencia universal, pero preocupa en Latinoamérica”, alertó la investigadora.
La indagación científica también reconoce que el “lento y trabajoso” proceso de identificación de un antibiótico, así como su alto costo de desarrollo, está favoreciendo a los microorganismos.
Como recomendación a los Gobiernos, el equipo de expertos ha pedido que se creen mecanismos de contención nacional para este tipo de bacterias y fomentar políticas de higiene hospitalaria y de aislamiento de pacientes afectados.
Los datos revelados por el grupo de investigación coinciden con la Semana Mundial de Concienciación sobre el Uso de los Antibióticos de 2017. efe
EFE
EFE